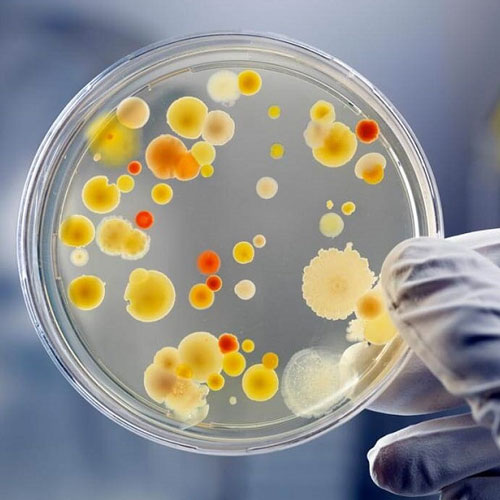

Why Choose Smart Lab?
Smart Lab is a testing and adjustment research facility with over twenty years of involvement with offering types of assistance across the globe.
Smart Lab is a testing and adjustment research facility with over twenty years of involvement with offering types of assistance across the globe.
We utilize advanced technology and rigorous testing protocols to deliver precise and reliable results.
Our team consists of skilled professionals with extensive experience in their respective fields, ensuring the highest level of expertise and quality service.
We adhere to strict quality management systems and follow industry standards and regulations to ensure compliance and reliability in our testing processes.
We understand that every client and project is unique. That's why we offer customized testing solutions tailored to meet specific requirements and objectives.
We prioritize efficiency and strive to deliver results in a timely manner, helping our clients meet deadlines and make informed decisions promptly.
At Smart Lab, we specialize in providing comprehensive testing services to ensure the quality, safety, and compliance of various products and materials. With state-of-the-art equipment and a team of experienced professionals, we deliver accurate and reliable results to meet our clients' needs across diverse industries.
In today's competitive landscape, quality assurance is paramount. At Smart Lab, we understand the importance of delivering reliable results swiftly and efficiently.
In the petroleum industry, precise testing and analysis are critical to ensuring the integrity and performance of fuels, lubricants, and other petroleum products. Smart Lab provides a comprehensive suite of testing services.
We recognize the importance of timely and accurate results . With our efficient scheduling, streamlined processes, and commitment to prompt reporting, we ensure that you receive your imaging results in a timely manner, allowing for swift diagnosis and treatment planning.
Doctors
Facilities & Services
Happy Customers
Awards

Material TestingFrom metals and polymers to ceramics and composites, we offer a wide range of material testing services to assess mechanical properties, chemical composition, and more.

Our environmental testing services help businesses assess the impact of their products and processes on the environment. We conduct tests for air quality, water quality, soil contamination, and more.

Ensure your products meet industry standards and regulations with our comprehensive product testing services. We evaluate performance, durability, safety, and compliance across various product categories.

Our chemical analysis services provide detailed insights into the composition and purity of substances, helping businesses maintain quality control and meet regulatory requirements.
We offer microbiological testing to detect and identify microorganisms in products, water, and environmental samples, ensuring safety and hygiene standards are met.

Keep your equipment and instruments accurate and reliable with our calibration services. We calibrate a wide range of instruments to ensure traceability and compliance with international standards.